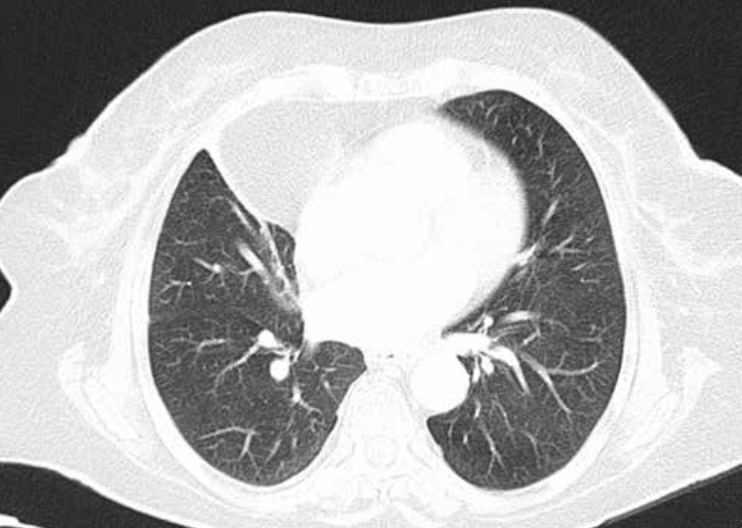
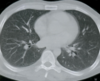

Rx normal.
Radiografía posteroanterior.
Es la proyección más utilizada. Convencionalmente se realiza en bipedestación, en inspiración profunda y a larga distancia para minimizar la magnificación.

Rx normal.
Radiografía anteroposterior.
Se reserva para los casos en que no se puede hacer una proyección PA, fundamentalmente para pacientes encamados e inmovilizados, para lo que además se usan aparatos portátiles, de menor calidad.
¡OJO! Es un error frecuente diagnosticar de insuficiencia cardiaca a un paciente por culpa de una radiografía AP, ya que los hallazgos son similares. Presta atención a la proyección sobre todo si te hablan de un paciente encamado.

Radiografía en decúbito lateral que evidencia derrame.
Se trata de proyecciones poco frecuentes. Toman su nombre del lado apoyado en la cama. Permiten visualizar aire o líquido en la caja torácica: para ver aire en un hemitórax, se pide un decúbito lateral con el otro hemitórax apoyado (el aire sube); para ver líquido en un hemitórax, se pide un decúbito del mismo lado (el líquido baja y se acumula bajo el pulmón, junto a la caja torácica).
Principales proyecciones radiológicas


Radiografía en espiración de un neumotórax izquierdo.
Neumotórax. Se distingue mejor en espiración, ya que al aparecer el parénquima pulmonar más denso, contrasta más con el aire extrapulmonar.
Si auscultas una sibilancia unilateral, pide una placa en espiración para descartar atrapamiento aéreo.
Orden de estudio de una placa de tórax
- Abdomen superior
- Pared Torácica (tejidos blandos y huesos)
- Mediastino
- Pulmón unilateral
- Pulmón bilateral
¿Alguien Tiene Mocos Por Pulmonía?
El índice cardiotorácico (ICT) es..
El índice cardiotorácico (ICT) es la relación que existe entre el diámetro transverso del corazón y el diámetro transverso del tórax. Para calcularlo mide la anchura horizontal del corazón y divídela entre el diámetro interno más ancho del tórax. Un índice cardiotorácico normal debe ser inferior a 0,5.

Observa y nombra la silueta de las diferentes estructuras que forman el mediastino.

El borde derecho está formado de arriba hacia abajo por el tronco braquiocefálico derecho, la vena cava superior (VCS), la aurícula derecha (AD) y una pequeña parte de la vena cava inferior (VCI).
En el lado izquierdo la parte superior representa la silueta de la arteria subclavia (A Sc) que se continúa con la prominencia del botón aórtico (B Ao).
En la parte media se proyecta el tronco de la arteria pulmonar (AP); parte de la aurícula izquierda (AI) y el ventrículo izquierdo (VI), que forma un arco fuertemente prominente y delimita el ápex cardiaco.

VCS: Vena cava superior. AD: aurícula derecha. VCI: Vena cava inferior. A Sc: Arteria subclavia. B Ao: Botón aórtico. AP: Arteria pulmonar. AI: Aurícula izquierda. VI: Ventrículo izquierdo. VD: ventrículo derecho.
Observa y nombra la silueta de las diferentes estructuras que forman el mediastino en radiografía lateral.

Mediastino en radiografía lateral.
A: Corazón. B: Cayado aórtico. C: Tráquea. D: Hilio. E: Ángulo costofrénico. F: Diafragma izquierdo. G: Diafragma derecho. H: Hígado. I: Burbuja gástrica.

Patrón intersticial

Traduce la afectación selectiva del intersticio pulmonar que aumenta de espesor y se hace más visible. Los alveolos, llenos de aire, y el pulmón sigue apareciendo bien aireado. El aspecto básico un pulmón aireado pero con demasiada trama.
Patrón alveolar

Cuando por alguna razón los alveolos se ocupan por líquido o tejido (sangre, edema, moco, tumor…) los pulmones dejan de estar aireados y aparecen blancos de forma homogénea.
Ahora el intersticio se hace menos visible porque tiene la misma densidad que los alveolos. Puede aparecer signo del broncograma aéreo.
Hay cuatro densidades radiológicas básicas..
..aire, grasa, agua y calcio.
Signo de la silueta en placa de tórax PA.

Neumonía del lóbulo inferior izquierdo. La consolidación del lóbulo inferior izquierdo borra el contorno del hemidiafragma izquierdo (infiltrado retrocardiaco).
Signo de la silueta en placa de tórax PL.

Neumonía del lóbulo inferior izquierdo. La consolidación del lóbulo inferior izquierdo borra el contorno de la aorta descendente (infiltrado retrocardiaco).

Consolidación del lóbulo medio en la que se aprecia el signo del broncograma aéreo. La visualización de aire en los bronquios intrapulmonares en una radiografía de tórax se llama signo del broncograma aéreo.
En una radiografía normal las estructuras ramificadas que se observan en los pulmones se corresponden con los vasos (de densidad agua). Los bronquios intrapulmonares no se observan ya que contienen aire, están rodeados por el aire alveolar y sus paredes son tan finas que no hay contraste que los haga visibles.
Cuando los alveolos se llenan de líquido esta situación se invierte: dejamos de ver los vasos (que ahora tienen la misma densidad que los alveolos ocupados), y se hacen visibles los bronquios (al contener aire que contrasta con el líquido alveolar).

Consolidación con pérdida de volumen y lesiones cavitadas en lóbulo superior derecho. Además, se observa consolidación periférica basal derecha.
Ante una lesión cavitada debes:
- Valorar el grosor de la pared. Una pared gruesa e irregular sugiere neoplasia, mientras que los neumatoceles o quistes broncogénicos tienen paredes finas y más regulares.
- Valorar el contenido. Aparte del nivel hidroaéreo, un hallazgo típico aunque raro es el del aspergiloma, en forma de bola blanca en el interior.
Causas de lesiones pulmonares cavitadas
- Absceso, infección por hongos o micobacterias
- Neoplasia
- Neumonía necrotizante
- Infarto pulmonar
- Enfermedad de Wegener
- Nódulos reumatoides
- Neumoconiosis
- Sarcoma de Kaposi
Cuando una masa o nódulo pulmonar es muy periférico, hay que diferenciarlo de una lesión extrapulmonar…

Nos fijaremos en el ángulo que forma la lesión con la pared torácica:
- Obtuso. Orienta hacia masa extrapulmonar.
- Agudo. Probablemente esté dentro del parénquima pulmonar.
Arriba: masa extrapulmonar (ángulo obtuso con la pared torácica). Abajo: masa intraparenquimatosa (ángulo agudo).

Hiperinsuflación. Patologías como el asma o el enfisema pueden cursar con un exceso de aire en los pulmones.
Sus hallazgos radiológicos son:
- Aplanamiento del hemidiafragma. Veremos el hemidiafragma derecho por debajo de la séptima costilla anterior.
- Horizontalización de costillas y aumento del espacio intercostal.
- Estrechamiento de la silueta cardiaca.
- Ensanchamiento del espacio aéreo retroesternal o retrocardiaco en proyección lateral.

Hiperinsuflación. Patologías como el asma o el enfisema pueden cursar con un exceso de aire en los pulmones.
TC ventana pulmonar
Se ven mejor la vía aérea, vasos pulmonares y cisuras, pero todas las estructuras mediastínicas aparecen de un tono gris demasiado similar.
TC ventana mediastínica
Permite diferenciar las estructuras mediastínicas entre sí, pero el parénquima pulmonar aparece todo negro, sin apenas trama broncovascular.


Principales utilidades de TC de alta resolución?
Imagen de TC de alta resolución que muestra fibrosis pulmonar.
Principales utilidades de TC de alta resolución son:
- Valorar el grado de afectación de enfermedades intersticiales pulmonares.
- En pacientes EPOC, para valorar el grado de enfisema y pequeñas zonas de atrapamiento aéreo.
- Determinar la gravedad y extensión de bronquiectasias.
- Valorar qué área es más rentable biopsiar.

Principales utilidades de TC de alta resolución?
Imagen de TC de alta resolución que muestra fibrosis pulmonar.
Principales utilidades de TC de alta resolución son:
- Valorar el grado de afectación de enfermedades intersticíales pulmonares.
- En pacientes EPOC, para valorar el grado de enfisema y pequeñas zonas de atrapamiento aéreo.
- Determinar la gravedad y extensión de bronquiectasias.
- Valorar qué área es más rentable biopsiar.